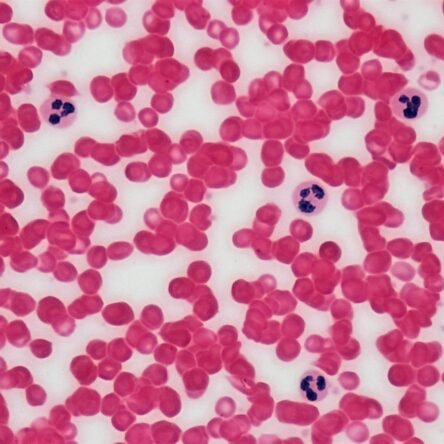
Blood Picture (P/S) Gbp

The Growth & Metabolic Panel (Second Trimester)Read More
The Growth & Metabolic Panel (Second Trimester)Read MoreDesigned for the "Golden Phase" of pregnancy (Weeks 13–27), this panel focuses on how your body is adapting to rapid fetal growth. It is the essential screening tool for Gestational Diabetes, genetic safety (Quad Screen), and physiological anemia.
 Pregnancy Wellness Package 1Read More
Pregnancy Wellness Package 1Read MoreThis all-inclusive Pregnancy Wellness Package covers 63 vital health parameters designed to ensure the safety of both mother and baby. It screens for anemia, nutritional deficiencies (Iron, Vitamin D, B12), thyroid health, infectious diseases, and genetic blood disorders. It is the gold standard for First Trimester or Early Pregnancy monitoring.
 Kashmir Starter 1.1 Wellness ProfileRead More
Kashmir Starter 1.1 Wellness ProfileRead More-
Genetic 1.1 Package (59 Parameters)
-
Complete Blood Count (CBC): Assesses overall blood health and immunity.
-
Liver Function Test (LFT): Screen for liver health and enzymes.
-
Kidney Function Test (KFT): Evaluates kidney filtration and electrolytes.
-
Thyroid Function Tests (TFT): Checks thyroid hormone levels (T3, T4, TSH).
-
Lipid Profile: Measures cholesterol for heart health.
-
Iron Deficiency Profile: Detects anemia and iron levels.
-
-
 Kashmir Vital 1.2 Wellness ProfileRead More
Kashmir Vital 1.2 Wellness ProfileRead MoreGenetic 1.2 Package (60 Parameters)
-
HbA1c: Long-term blood sugar & diabetes monitoring.
-
Complete Blood Count (CBC): Overall blood health and immunity check.
-
Liver Function Test (LFT): assessed liver enzymes and health.
-
Kidney Function Test (KFT): Evaluates kidney filtration ability.
-
Thyroid Function Tests: Checks key thyroid hormones.
-
Lipid Profile: Assesses cholesterol and heart disease risk.
-
Iron Deficiency Profile: Screens for anemia and iron stores.
-
 Kashmir Comprehensive 1.3 Wellness ProfileRead More
Kashmir Comprehensive 1.3 Wellness ProfileRead MoreGenetic 1.3 Package (62 Parameters)
-
Vitamin Profile: Checks for Vitamin D & Vitamin B12 deficiencies.
-
HbA1c: Long-term blood sugar & diabetes monitoring.
-
Complete Blood Count (CBC): Overall blood health and immunity check.
-
Liver Function Test (LFT): Assesses liver enzymes and health.
-
Kidney Function Test (KFT): Evaluates kidney filtration ability.
-
Thyroid Function Tests: Checks key thyroid hormones.
-
Lipid Profile: Assesses cholesterol and heart disease risk.
-
Iron Deficiency Profile: Screens for anemia and iron stores.
-
Biochemistry
-
 Sale!
Sale!CEA (Carcinoembryonic Antigen) – Tumor Marker
Price:₹1,550.00Original price was: ₹1,550.00.₹450.00Current price is: ₹450.00. -
 Sale!
Sale!Double Marker Test / First Trimester Maternal Serum Screening
Price:₹1,800.00Original price was: ₹1,800.00.₹1,100.00Current price is: ₹1,100.00. -
 Sale!
Sale!Triple Marker Test
Price:₹2,800.00Original price was: ₹2,800.00.₹1,500.00Current price is: ₹1,500.00. -
 Sale!
Sale! -
 Sale!
Sale!Lipid Profile / Lipid Panel
Price:₹450.00Original price was: ₹450.00.₹250.00Current price is: ₹250.00. -
 Sale!
Sale!Kidney Function Test (KFT)
Price:₹250.00Original price was: ₹250.00.₹150.00Current price is: ₹150.00. -
 Sale!
Sale!Liver Function Test (LFT)
Price:₹500.00Original price was: ₹500.00.₹260.00Current price is: ₹260.00. -
 Sale!
Sale! -
 Sale!
Sale! -
 Sale!
Sale!
Haematology
-
 Sale!
Sale!CD3 / CD4 / CD8 Panel (T-Lymphocyte Helper/Suppressor Profile)
Price:₹2,550.00Original price was: ₹2,550.00.₹1,800.00Current price is: ₹1,800.00. -
 Sale!
Sale!Blood Group (Abo & Rh Factor)
Price:₹100.00Original price was: ₹100.00.₹60.00Current price is: ₹60.00. -
-
 Sale!
Sale!Anti Thrombin III
Price:₹2,850.00Original price was: ₹2,850.00.₹1,850.00Current price is: ₹1,850.00. -
 Sale!
Sale!Absolute Eosinophil Count Blood
Price:₹150.00Original price was: ₹150.00.₹100.00Current price is: ₹100.00. -

-
 Sale!
Sale!
Serology
-
 Sale!
Sale!Male Hormonal Profile (FSH, LH, Prolactin, Total & Free Testosterone)
Price:₹2,800.00Original price was: ₹2,800.00.₹1,500.00Current price is: ₹1,500.00. -
 Sale!
Sale!Chikungunya Igg & Igm Quantitative
Price:₹2,080.00Original price was: ₹2,080.00.₹1,550.00Current price is: ₹1,550.00. -
 Sale!
Sale!Chikungunya Igm (Qualitative)
Price:₹600.00Original price was: ₹600.00.₹450.00Current price is: ₹450.00. -
 Sale!
Sale!Brucella Antibody (Total) By Agglutination
Price:₹1,080.00Original price was: ₹1,080.00.₹650.00Current price is: ₹650.00. -
 Sale!
Sale! -
 Sale!
Sale!Anti Streptolysin O (Aso) – Quantitative
Price:₹460.00Original price was: ₹460.00.₹280.00Current price is: ₹280.00. -
 Sale!
Sale!Anti Streptolysin O (Aso) Titre
Price:₹460.00Original price was: ₹460.00.₹250.00Current price is: ₹250.00. -
 Sale!
Sale!Anti Hepatitis E Virus (Anti Hev) – Igm
Price:₹1,400.00Original price was: ₹1,400.00.₹800.00Current price is: ₹800.00. -
 Sale!
Sale!Anti-IA-2 (Insulinoma-Associated-2 Antibody)
Price:₹14,040.00Original price was: ₹14,040.00.₹9,500.00Current price is: ₹9,500.00. -
 Sale!
Sale!Anti Neutrophilic Cytoplasmic Antibodies (ANCA)
Price:₹1,560.00Original price was: ₹1,560.00.₹900.00Current price is: ₹900.00.
Immunology
-
 Sale!
Sale!Triple Marker Test
Price:₹2,800.00Original price was: ₹2,800.00.₹1,500.00Current price is: ₹1,500.00. -
 Sale!
Sale! -

-
 Sale!
Sale!Cea (Carcino Embryonic Antigen) – Cancer Markers
Price:₹850.00Original price was: ₹850.00.₹600.00Current price is: ₹600.00. -
 Sale!
Sale!Ceruloplasmin (Copper Oxidase)
Price:₹1,300.00Original price was: ₹1,300.00.₹650.00Current price is: ₹650.00. -

-
 Sale!
Sale! -
 Sale!
Sale!Ca19.9 (Pancreatic Cancer) – Cancer Markers
Price:₹700.00Original price was: ₹700.00.₹480.00Current price is: ₹480.00. -
 Sale!
Sale!Beta 2 Microglobulin Serum
Price:₹700.00Original price was: ₹700.00.₹450.00Current price is: ₹450.00. -
 Sale!
Sale!
Microbiology
-
 Sale!
Sale!Mid-Stream Urine (MSU) – Routine, Microscopy & Culture
Price:₹350.00Original price was: ₹350.00.₹150.00Current price is: ₹150.00. -
 Sale!
Sale! -
 Sale!
Sale!Blood Culture & Sensitivity (Auto)
Price:₹600.00Original price was: ₹600.00.₹450.00Current price is: ₹450.00. -

-
 Sale!
Sale!Afb Detection (Zn Stain)
Price:₹170.00Original price was: ₹170.00.₹100.00Current price is: ₹100.00. -
 Sale!
Sale!Albert Stain (C.Diphtheriae)
Price:₹500.00Original price was: ₹500.00.₹250.00Current price is: ₹250.00. -
 Sale!
Sale!Acid Fast Susceptibility – 10 Drugs (Bactec)
Price:₹10,800.00Original price was: ₹10,800.00.₹6,500.00Current price is: ₹6,500.00. -
 Sale!
Sale!Acid Fast Susceptibility – 5 Drugs (Bactec)
Price:₹6,800.00Original price was: ₹6,800.00.₹4,500.00Current price is: ₹4,500.00.
Immunoassay
-
 Sale!
Sale!Male Hormonal Profile (FSH, LH, Prolactin, Total & Free Testosterone)
Price:₹2,800.00Original price was: ₹2,800.00.₹1,500.00Current price is: ₹1,500.00. -
 Sale!
Sale! -
 Sale!
Sale!TSH (Thyroid-stimulating hormone)
Price:₹200.00Original price was: ₹200.00.₹120.00Current price is: ₹120.00. -
 Sale!
Sale!TORCH-4 IgM Panel, Serum (ELISA)
Price:₹1,200.00Original price was: ₹1,200.00.₹900.00Current price is: ₹900.00. -
 Sale!
Sale!Chlamydia Pneumoniae -Igg
Price:₹1,300.00Original price was: ₹1,300.00.₹900.00Current price is: ₹900.00. -
 Sale!
Sale!Chlamydia Pneumoniae-Igm
Price:₹1,300.00Original price was: ₹1,300.00.₹900.00Current price is: ₹900.00. -
 Sale!
Sale!Chlamydia Trachomatis Igg Antibody
Price:₹2,223.00Original price was: ₹2,223.00.₹1,550.00Current price is: ₹1,550.00. -
 Sale!
Sale!Cardiolipin Antibody Acl-Igg Antibody
Price:₹700.00Original price was: ₹700.00.₹560.00Current price is: ₹560.00. -
 Sale!
Sale!Cardiolipin Antibody Acl-Igm Antibody
Price:₹1,300.00Original price was: ₹1,300.00.₹850.00Current price is: ₹850.00. -
 Sale!
Sale!Catecholamines 24 Hour
Price:₹3,400.00Original price was: ₹3,400.00.₹2,200.00Current price is: ₹2,200.00.
Histopathology
Biopsies...
-
 Sale!
Sale! -
 Sale!
Sale!Biopsy Large (>2.5 Cm)
Price:₹3,400.00Original price was: ₹3,400.00.₹1,500.00Current price is: ₹1,500.00. -
 Sale!
Sale!Biopsy Medium (0.6-2.4 Cm)
Price:₹950.00Original price was: ₹950.00.₹650.00Current price is: ₹650.00. -
 Sale!
Sale! -
 Sale!
Sale! -
 Sale!
Sale!
Cytology
-

-
 Sale!
Sale!Buccal Smear For Barr Bodies (Sex Chromatin)
Price:₹900.00Original price was: ₹900.00.₹450.00Current price is: ₹450.00. -
 Sale!
Sale!Bone Marrow Aspiration
Price:₹1,900.00Original price was: ₹1,900.00.₹900.00Current price is: ₹900.00. -
 Sale!
Sale!Bone Marrow Smear Microscopy Examination
Price:₹1,550.00Original price was: ₹1,550.00.₹1,050.00Current price is: ₹1,050.00. -

Kashmir Health Blog
Latest from the Blog Posts
Awards & Recognition


















